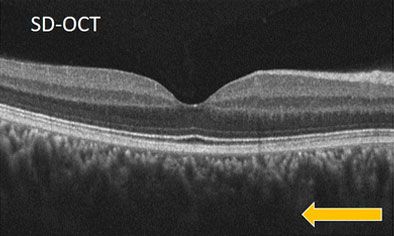
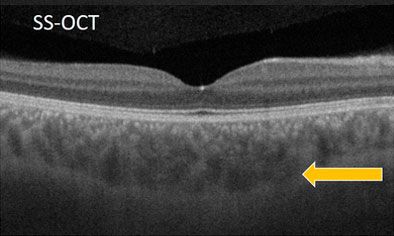

Оптическая когерентная томография (ОКТ) давно стала неотъемлемой частью современной офтальмологической диагностики. Однако при выборе томографа внимание зачастую сосредоточено на привычных характеристиках: разрешение, скорость, доступные карты и индексы. Мало кто задумывается, какая технология лежит в основе прибора — Spectral Domain (SD OCT) или Swept Source (SS OCT).
Между тем именно технология определяет ключевые параметры: глубину проникновения сканирующего луча, стабильность разрешения по всей глубине, чувствительность к помутнению оптических сред. Она влияет на то, насколько достоверным будет изображение и какие структуры глаза врач сможет реально визуализировать.
Вместе с продакт-менеджером MEDEQ по офтальмологии Андреем Сюзевым рассказываем, в чём заключается принципиальная разница между SD и SS OCT и почему технология имеет значение в ежедневной практике врача, анализируем актуальные научные исследования, а также приводим примеры современных томографов, работающих на платформе Swept Source.
Андрей Сюзев,
продакт-менеджер MEDEQ
по офтальмологическому оборудованию
Современные технологии оптической когерентной томографии прошли значительный путь за последние два десятилетия. До 2006 года в офтальмологической практике использовались преимущественно устройства Time Domain OCT, но их ограниченные возможности по скорости и разрешению не позволяли проводить полноценную диагностику на глубоком уровне.
Настоящий прорыв произошёл с появлением Spectral Domain OCT (SD OCT) в 2006 году. Эта технология заменила механическое сканирование на спектральный анализ отражённого сигнала, что позволило резко увеличить скорость получения изображений и улучшить детализацию структур сетчатки. SD OCT стал новым стандартом, широко внедрившись в клиническую практику во всём мире.
Однако к 2012 году офтальмология сделала ещё один шаг вперёд: на рынок вышли томографы с технологией Swept Source OCT (SS OCT). В отличие от SD OCT, они используют инфракрасный лазер с быстро изменяющейся длиной волны, что обеспечивает более глубокое проникновение сигнала в ткани и повышает качество изображения на всём протяжении скана. Именно с появлением SS OCT стало возможным получить чёткие визуализации хориоидеи, заднего полюса глаза и проводить полноценную ангиографию (ОКТА) даже у пациентов с непрозрачными средами.
Чтобы понять разницу между двумя технологиями, важно разобраться в их базовых физических принципах.
SD OCT основан на использовании суперлюминесцентного диода, излучающего когерентный свет в красном (видимом) диапазоне спектра с фиксированной длиной волны. Сигнал, отражённый от различных слоёв сетчатки, проходит через интерферометр и анализируется с помощью спектрометра. Благодаря спектральному анализу удаётся быстро и точно построить изображение внутренних структур глаза без необходимости механического перемещения сканирующего элемента.
Однако у этой технологии есть ограничения:
SS OCT использует в качестве источника света лазер в инфракрасном (невидимом) диапазоне, у которого длина волны быстро и динамично изменяется в процессе сканирования. Это позволяет поочерёдно «просвечивать» ткани на разных глубинах с высокой точностью.
Главные преимущества этой технологии:

При SD-OCT хориоидея визуализируется слабо — размыты границы, особенно в глубоких слоях. При SS-OCT сосудистая оболочка чётко прослеживается по всей толщине до склеры благодаря высокой проникающей способности инфракрасного лазера.
Различия между SD и SS OCT — это не просто технические детали, а реальные отличия, которые ощущаются в ежедневной работе врача и в опыте пациента.
Ряд независимых исследований подтвердил: технология Swept Source OCT превосходит SD OCT по глубине визуализации, стабильности разрешения и диагностической информативности. Особенно это заметно при оценке хориоидеи, пациентов с миопией, катарактой и в ангиографическом анализе.
Улучшенная визуализация хориоидеи при её утолщении более 400 мкм. В исследовании пациентов с пахихороидными патологиями ( PLOS ONE, 2019) технология SS OCT позволила уверенно определить хориосклеральную границу даже при толщине хориоидеи более 400 мкм. SD OCT в аналогичных условиях демонстрировал значительные сложности или полную невозможность чёткой визуализации границы, что объясняется лучшей глубиной проникновения и стабильностью сигнала SS OCT.
Сниженные артефакты и более чёткая визуализация сосудов при движении глаз. Обзор 2023 года, опубликованный в Frontiers in Medicine, отметил, что Swept Source OCT обладает значительно меньшей чувствительностью к движению пациента, обеспечивая высококачественные изображения сосудистой сети даже при нестабильной фиксации. Это связано с высокой скоростью сканирования до 400 тыс. A-сканов/сёк, что примерно в 3–4 раза быстрее, чем у традиционного SD OCT.
Повышенная точность и воспроизводимость измерений толщины хориоидеи у пациентов с миопией. Согласно данным исследования 2021 года в журнале Scientific Reports, SS OCT демонстрирует высокую воспроизводимость измерений толщины хориоидеи и существенно меньшую вариативность повторных измерений по сравнению с SD OCT. Это важно для объективного динамического мониторинга пациентов и сокращения времени исследований.
Широкоугольные панорамные снимки с охватом до 24 мм — преимущество при обследовании миопии. В обзоре, опубликованном в ScienceDirect (2022), подчёркивается способность SS OCT получать единым сканом панорамные изображения шириной до 23–24 мм, тогда как возможности SD OCT ограничены максимум 12 мм. Широкий охват существенно улучшает диагностику патологий заднего сегмента глаза, особенно при высокой степени миопии и патологических изменениях стекловидного тела.
Сегодня на рынке есть несколько моделей томографов, работающих по технологии Swept Source OCT. Приводим обзор трёх актуальных решений, которые уже используются в российских клиниках и доступны для заказа в MEDEQ.

TowardPi Yalkaid YG-100K Глубина сканирования: до 14 мм — с визуализацией хориоидея и заднего полюса
Скорость: 100 000 A-сканов/сек
Особенности: встроенная OCT-ангиография, автоматическое распознавание структур, возможность работы при непрозрачных средах
Кому подойдёт: многопрофильным офтальмологическим центрам, работающим с пациентами с миопией, диабетом, сосудистыми изменениями

TowardPi BMizar BM-400K Скорость сканирования: до 400 000 A-сканов/сёк — один из самых быстрых томографов в мире
Дополненное цифровое разрешение: 1,4 мкм — почти в 3 раза выше, чем у лучших SD OCT
Визуализация: OCT, OCTA и панорамные широкоугольные сканы до 24 мм
SLO-модуль: совмещение с фундус-снимками для точного сопоставления структур
AS-OCTA: можно визуализировать

Topcon DRI OCT Triton Один из первых массовых SS OCT, проверенный в мировой практике
ОКТА + глубокое сканирование: поддержка ангиографии и визуализация заднего полюса при миопии
Встроенная база данных: автоматические отчёты, встроенные референсные карты
Кому подойдёт: учреждениям, переходящим от SD OCT к SS OCT, но опасающимся новых производителей и предпочитающим проверенный временем вариант, хоть и отстающий от них функционально.